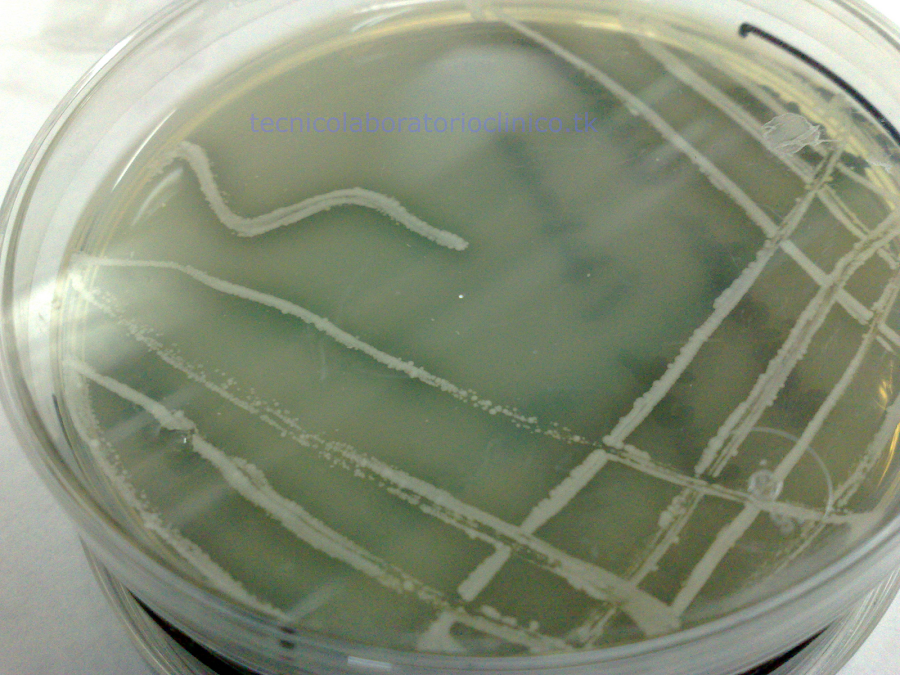

(Mahatma Gandhi)
MICROBIOLOGÍA DE LOS ALIMENTOS
(Parte 17)
Mohos y Levaduras
Las levaduras y los mohos, constituyentes de la flora micótica total a investigar, generalmente se han cultivado en medios de pH bajo (3,5 - 5,5) y a temperaturas de 20° - 30º C si bien muchas bacterias crecen en estas condiciones. Para inhibir las bacterias se utilizan antibióticos de amplio espectro que incorporados a los medios de cultivo inhiben el crecimiento de aquéllas. Un medio típico es el agar oxitetraciclina-glucosa-extracto de levadura, que lleva como agente selectivo oxitetraciclina y entre otros nutrientes glucosa y que se ajusta a un pH relativamente alto, aproximadamente 6,5. Los métodos de ensayo de las aflatoxinas difieren algo, dependiendo del alimento. Generalmente el alimento se pica suficientemente y a continuación se extrae con un solvente adecuado, como el cloroformo. Se purifica el extracto y la fase siguiente de detección implica algún tipo de cromatografía, generalmente en capa fina. Con el empleo de solventes que separan netamente las toxinas, se pueden comparar cualquier tipo de manchas que den fluorescencia bajo la luz UV con los correspondientes estándares. El significado de la contaminación fúngica de los alimentos, especialmente por mohos, viene no sólo del potencial de los mohos para deteriorar los alimentos, sino también del potencial de muchos de ellos para producir una gran variedad de micotoxinas a las que el hombre es sensible, así como su capacidad para provocar infecciones e incluso, reacciones alérgicas a personas hipersensibles a los antígenos fúngicos. En cuanto al significado para la salud del consumidor, la acción de las levaduras es meramente infectiva.
De todo esto se deduce que existe un riesgo potencial en la contaminación fúngica de los alimentos y, por ello, para conocer la calidad microbiológica de diversos productos, se procede a la evaluación de su tasa de contaminación por mohos y levaduras. Después del recuento se puede realizar una identificación aproximada de las colonias de levaduras y mohos que aparecen en la placa. La identificación de las levaduras conlleva una serie de pruebas fisiológicas y bioquímicas, por lo que la metodología en este punto se aproxima, en cierta medida, a los sistemas clásicos de identificación bacteriana. Las técnicas de identificación de mohos se encaminan, casi exclusivamente, al estudio de la morfología, tanto macroscópica como microscópica: crecimiento, aspecto de las colonias, características de las hifas, formación de exudado, pigmentos, micelio, esporas, etc.
Procedimiento: La siembra de las placas de recuento se lleva a cabo en masa. A partir de la serie de diluciones decimales se añade 1 ml de la dilución 1/10 y 1/100 en sendas placas de Petri vacías en las que se añade medio Rosa de Bengala con cloranfenicol (20 ml/placa aproximadamente) atemperado a 45 - 47ºC. Las placas se incuban, SIN INVERTIRLAS, a 24ºC durante 4 - 5 días. El recuento se realiza en la placa que presente un crecimiento entre 0 - 50 colonias. El crecimiento de mohos y levaduras se caracteriza por el aspecto algodonoso y cremoso de sus colonias, respectivamente. Para la identificación de mohos se coge un trozo periférico de una colonia y se homogeneiza en un portaobjetos sobre el que previamente se ha añadido una gota de lactofenol. Se protege la preparación con un cubre evitando que queden burbujas de aire. Se le añade una gota de aceite de inmersión y se observan al microscopio las esporas, los cuerpos fructíferos, el micelio, etc.
Clostridios Sulfito – Reductores
Contrariamente a lo que sucede con las salmonelas el aislamiento de un pequeño número de C. perfringens a partir de los alimentos no significa necesariamente que exista peligro de toxiinfección alimentaria; sólo cuando hay un gran número existe verdadero peligro, por lo que con este microorganismo las técnicas de recuento son imprescindibles. Se emplean las siembras (en placa, por vertido o en superficie) de diluciones de homogeneizados del alimento, junto con medios selectivos. Se han desarrollado muchos de estos medios para C. perfringens: la mayoría a base de agar, al que se incorporan los nutrientes más convenientes, sistemas indicadores y agentes selectivos. La ICMSF ha estudiado comparativamente los métodos de enumeración de C. perfringens de los alimentos y ha concluido que el agar sulfito-cicloserina proporciona las mayores recuperaciones de esta bacteria, además del número más bajo de falsos positivos. Este medio contiene cicloserina, un antibiótico, y además un sistema indicador que se basa en que C. perfringens, como otros muchos clostridios, reduce el sulfito o sulfuro, dando colonias negras en presencia de una sal de hierro. Después de la incubación de las placas en anaerobiosis a 37 ºC durante 24 horas, las colonias sospechosas se inoculan en un medio confirmativo, observando la movilidad (C. perfringens es inmóvil) y la capacidad de reducir los nitratos a nitritos. Otra prueba confirmatoria consiste en sembrar las colonias sospechosas en placas de agar yema de huevo, a una de cuyas mitades se le añade antitoxina de C. perfringens. Después de la incubación las colonias crecidas en la mitad de la placa carente de antitoxina, están rodeadas de una zona opaca (reacción de Nagler), mientras que las de la otra mitad no muestran cambios ya que la reacción ha sido específicamente neutralizada por la antitoxina. C. botulinum corrientemente no se enumera en los alimentos y las pruebas que con él se emplean implican generalmente la detección de toxinas botulínicas en el alimento y el aislamiento de C. botulinum, seguido de la detección de sus toxinas.
Debe tenerse un cuidado extremo al analizar los alimentos sospechosos y es necesario el consejo de un experto antes de embarcarse en tales análisis. Si se dispone de buen laboratorio los homogeneizados de alimentos se pueden examinar directamente al microscopio poniendo de manifiesto la presencia de células enteras y de esporas con ayuda de las técnicas de tinción fluorescente. También deben sembrarse en estría muestras de alimentos en agar sangre, preferiblemente con yema de huevo para que se obtenga después de una incubación de 3 días a 30º C en anaerobiosis la típica reacción de color de C. botulinum (esto es, una zona opaca alrededor de la colonia y una capa perlacea en la superficie). Las colonias sospechosas se siembran después en caldo de carne cocida y en el líquido sobrenadante se investiga la presencia de toxina botulínica después de un tiempo de incubación suficiente. (el ensayo de la toxina se realiza a veces en caldo de carne inoculado directamente con muestras del alimento sospechoso). Finalmente, en los extractos del alimento original puede intentarse el ensayo directo de la toxina. En esencia los ensayos implican la inoculación de los extractos del alimento o de los sobrenadantes de los cultivos a ratones, de los que algunos se han protegido con antitoxinas A, B o E mientras que otros no lo han sido. Los ratones inoculados se observan algunos días y si mueren los que no se protegieron con las correspondientes antitoxinas con los signos típicos de botulismo, mientras que viven los que lo fueron con la antitoxina específica, la prueba es positiva al correspondiente tipo de C. botulinum. Antes se han descrito los métodos de aislamiento de Clostridium botulinum, C. perfringens y Bacillus cereus, pero puede necesitarse la enumeración del número total de microorganismos esporulados del alimento. Como medida preliminar, las muestras o diluciones que los contengan deberán calentarse a 80º C durante 10 minutos para destruir todas las células vegetativas, después se enfrían y siembran. El calentamiento estimula la germinación de las esporas (choque térmico), proceso que frecuentemente es difícil de iniciar sin un estímulo adecuado. Para el recuento de Bacillus sp. se utilizan medios nutritivos estándar, incubándose aeróbicamente.
Obviamente los miembros de este grupo que se encuentran en forma vegetativa en los alimentos, no se incluyen en el recuento. Para los clostridios se necesita incubar en jarras cerradas cuyo aire es sustituido por hidrógeno. los clostridios anaerobios obligados requieren la inclusión en la jarra de un catalizador, como el paladio que convierte el oxígeno residual en agua, al combinarse con el hidrógeno. A veces se realiza un pre-enriquecimiento preliminar de la muestra, diluida en un medio de carne cocida, sin embargo, para verificar el recuento, es preferible la siembra directa en un medio sólido, nutritivamente complejo. Generalmente se emplea el medio diferencial reforzado para clostridios (Differential Reinforced Clostridial medium) de Gibbs y Freame (1965), que aunque líquido presenta muchas ventajas. los recuentos son mayores que en medios sólidos y no se requieren jarras anaeróbicas. No pueden hacerse recuentos exactos pero si se inoculan diluciones decimales se obtienen cifras que se encuentran en un rango de valores que difieren en un factor de diez (por ej., > 1.000 pero <10.000 por g). El medio contiene un sistema indicador a base de una fuente de azufre y una sal de hierro, de forma que el obscurecimiento del medio indica que han crecido clostridios la mayoría de los cuales producen ácido sulfhídrico. Las colonias de Clostridios sulfito reductores aparecerán de color negro debido a la formación de sulfuro ferroso por reducción del sulfito. Transcurridas 48 h, contar el número de colonias negras desarrolladas en la totalidad de la columna de agar, sin tener en cuenta las puntiformes. El resultado se expresará como número de esporas de clostridios sulfito reductores en el volúmen de agua sembrado (20 ml a 100ml). Con objeto de evitar la dificultad de recuento que puede producirse al confluir las colonias desarrolladas se efectuará una primera lectura a las 24 h, y si por este motivo no es posible el recuento a las 48 h se dará la lectura de las 24 h como resultado aproximado.
El grupo bacteriano de los sulfito – reductores está integrado por microorganismos pertenecientes al género Clostridium y que tienen en común reducir el sulfito a sulfuro. Son muy resistentes por su capacidad de esporular. Se suelen usar para apreciar la calidad higiénica del agua y productos animales. Su número es escaso en productos frescos. La capacidad de esporular de estos microorganismos les confiere una gran resistencia. La detección de Clostridium sulfito – reductores se logra utilizando medios de cultivo en cuya fórmula interviene el sulfito de sodio, como el medio SPS, en los que, por la capacidad de estos microorganismos de reducir tal sustancia, se produce sulfuro de hierro al actuar sobre el compuesto de hierro. La presencia de sulfuro de hierro se pone de manifiesto por la aparición del color negro de las colonias.
Pruebas Bioquímicas de Tipificación Bacteriana
Las pruebas bioquímicas consisten en distintos tests químicos aplicados a medios biológicos, los cuales, conocida su reacción, nos permiten identificar distintos microorganismos presentes, o sea, le damos su filiación, nombre y apellido, al microorganismo investigado. Su sistema de funcionamiento generalmente consiste en determinar la actividad de una vía metabólica a partir de un sustrato que se incorpora en un medio de cultivo y que la bacteria al crecer incorpora o no. Para realizar las pruebas bioquímicas se dispone de múltiples medios, los cuales se deben aplicar de acuerdo a las exigencias del microorganismo en estudio. De la amplia variedad de pruebas bioquímicas, estudiaremos los resultados que estos test arrojan.
Objetivos
· Realizar el experimento adecuadamente y poder identificar (aplicando éste método) a los distintos microorganismos, a los cuales podremos darles “nombre y apellido”.
· Debemos conocer cuáles de los test que componen las pruebas bioquímicas son los adecuados de acuerdo a la circunstancia que necesitemos estudiar.
· Entender los principios bioquímicos de las pruebas.
· Ser capaces de interpretar adecuadamente los resultados entregados por las pruebas bioquímicas
· Conocer el uso de las pruebas bioquímicas para la identificación de microorganismos
· Identificar errores de procedimiento en el laboratorio al realizar los experimentos y poder reconocer en que partes del procedimiento se cometió el o los errores, para así, mediante el desarrollo experimental conocer más profundamente las pruebas bioquímicas.
PRUEBA DE LA OXIDASA
Pone de manifiesto la presencia de enzima oxidasa en ciertos microorganismos. La oxidasa o citocromo oxidasa es una enzima que cede electrones (H2), de un substrato al oxígeno, en el tren de transporte electrónico. Pueden utilizarse diversos reactivos, que son colorantes que actúan como aceptores de electrones, pasando en este caso de forma incolora o poco coloreada, a fuertemente teñida. El reactivo más utilizado es el clorhidrato de tetrametil-p – fenilendiamina al 1 por 100 en agua (Reactivo de Kovacs). Existen comercializados discos o tiras de papel impregnadas de reactivos para el diagnóstico de oxidasa. Se coloca un trozo de papel de filtro Whatman Nº 1, dentro de una placa de Petri y se le añaden dos a tres gotas de reactivo. Con un asa de platino (que no sea de hierro, ya que puede dar falsos positivos), tomar una colonia de veinticuatro horas de desarrollo, y extenderla sobre el papel de filtro mojado. La aparición de una coloración púrpura sobre la línea de inoculación se considera como reacción positiva. Si no hay cambio de coloración, la prueba es negativa.
PRUEBA DE LA CATALASA
La catalasa es una enzima propia de la mayoría de las bacterias aerobias y anaerobias facultativas que poseen citocromos, con la excepción de Streptococcus. Su función es descomponer el peróxido de hidrógeno (H202), desprendiendo oxígeno libre. La prueba se puede realizar en porta o directamente sobre el cultivo. Se utiliza Agua oxigenada al 3 por 100 y se toma con el ansa una colonia de 24 horas de desarrollo y se deposita sobre un porta. Añadir con una pipeta una gota de agua oxigenada al 3 por 100; lo que no debe hacerse es homogeneizar el asa con el cultivo sobre una gota de H202 depositada previamente en el porta, pues produce falsos positivos. La prueba puede realizarse también añadiendo el agua oxigenada directamente sobre una placa que contiene un cultivo puro. Si la colonia procede de una placa de agar sangre puede dar falsos positivos debido a la presencia de eritrocitos, que también poseen catalasa. Se considera la prueba positiva cuando se observa desprendimiento de burbujas de gas (02).
PRUEBA DE ÓXIDO – FERMENTACIÓN (O – F) O DE HUGH LEIFSON
El medio de Hugh-Leifson es una base sin carbohidratos, a la que se puede añadir después de esterilizarlo cualquier azúcar esterilizado previamente por filtración. Cuando se habla de esta prueba sin especificar nada, hay que suponer que el test se ha hecho con glucosa, así, cuando se dice que un microorganismo es oxidante o fermentador se sobreentiende que lo es con respecto al metabolismo de la glucosa. Esta prueba pone de manifiesto la propiedad que tienen determinados microorganismos de actuar sobre los hidratos de carbono por vía oxidativa o fermentativa. Las bacterias que no presentan actividad sobre los glúcidos, dan esta prueba negativa. La prueba se realiza en dos tubos con medio semisólido y rectos, que inicialmente son de color verde. Se inoculan por picadura en el centro del tubo y uno de ellos se recubre con parafina líquida estéril (que impide el contacto del medio con el oxígeno atmosférico). El indicador en medio ácido (el metabolismo de los azúcares producen ácidos, tanto en presencia como en ausencia de oxígeno) es de color amarillo. Si el microorganismo es únicamente oxidante, después de la incubación sólo estará amarillo el medio sin cubrir con parafina, si es oxidante y fermentador, en los dos tubos el color vira a amarillo y si sólo puede utilizar el azúcar cuando no hay oxígeno sería fermentador (tubo con parafina amarillo). El medio de cultivo utilizado es el medio basal OF o de Hugh y Leifson. Inocular por picadura hasta 1/2 cm. del fondo del tubo. Para cada microorganismo se siembran dos tubos, uno de los cuales contiene parafina. Incubar a 37° C durante cuarenta y ocho horas o más. Los tubos se observan diariamente hasta los catorce días. El viraje de color azul verdoso a amarillo, indica que el microorganismo ha producido acidez a partir del azúcar. Si dicha coloración aparece solamente en el tubo que no está cubierto con parafina, diremos que el microorganismo actúa sobre la glucosa (o el azúcar utilizado) de forma oxidativa (O). Si se manifiesta en ambos, diremos que el germen es fermentativo (F).
UTILIZACIÓN DE LOS HIDRATOS DE CARBONO
Esta prueba determina la capacidad de un microorganismo para fermentar un hidrato de carbono específico, incorporado a un medio de cultivo base, produciendo ácido o ácido y gas. El indicador incluido en el medio es rojo de fenol, que a pH 7,4 es de color rosa – rojizo y a pH ácido vira a amarillo. Los hidratos de carbono más utilizados son: glucosa, lactosa, sacarosa, arabinosa, maltosa, manosa, rafinosa, fructosa, xilosa, trehalosa, galactosa, ramnosa, melobiosa, almidón, manitol, sorbitol, inositol, adonitol, inulina, salicina y amigdalina. Se prepara una solución al 10 por 100 del azúcar en agua destilada y se esteriliza por filtración y el medio de cultivo es el Caldo base púrpura de bromocresol. Una vez preparado el medio, se intuba a razón de 10 ml. en tubos que contengan una campana de Durham. Añadir asépticamente la solución estéril de carbohidrato para lograr una concentración final del 1 por ciento de azúcar. Inocular una o dos colonias con el ansa de platino y la incubación en cada caso se realiza a 37° C durante 24 – 48 horas.
La prueba nos permite observar:
· Producción de ácido: Medio de color amarillo.
· No producción de ácido: Medio de púrpura.
· Producción de gas (CO2 + H2): La presencia de aire dentro de la campana de Durham indica que el microorganismo produce gas del azúcar.
PRUEBA DE LA BETA-GALACTOSIDASA (ONPG)
Esta prueba demuestra la presencia de la enzima beta-galactosidasa en algunos microorganismos. Hay bacterias que a pesar de poseer enzimas hidrolizantes de la lactosa (beta - galactosidasas), no pueden actuar sobre ella porque les faltan las enzimas extracelulares apropiadas (permeasas). A estas bacterias se les denomina mutantes crípticos. Para conocer si un microorganismo es productor de betagalactosidasa, basta añadir el compuesto orgánico: O – nitrofenil – beta – D – galactopiranósido (ONPG) que es incoloro. Si la bacteria posee las enzimas hidrolizantes (beta – galactosidasa), el compuesto se transforma en ortonitrofenol, un derivado cromogénico de color amarillo. Todos los gérmenes denominados fermentadores lentos de la lactosa son beta-galactosidasa positivos. Se utilizan discos de ONPG, de los que se puede disponer comercializados. Preparar un inóculo muy denso en 1 ml. de solución salina estéril, y añadir asépticamente un disco de ONPG. Se favorece la reacción si la bacteria procede de un medio lactosado e incubar a 37° C de veinte minutos a veinticuatro horas. Si el microorganismo es productor de beta-galactosidasa, el líquido se volverá de color amarillo. Si queda incoloro, indicará que el microorganismo no posee la enzima.
PRUEBA DE LA PRODUCCIÓN DE INDOL
La prueba del indol determina la capacidad de las bacterias de degradar el triptófano dando indol. Algunas bacterias, gracias a la enzima triptofanasa hidrolizan el aminoácido, dando indol, ácido pirúvico y amoniaco. La presencia de indol se detecta observando la formación de una coloración rosa – roja en el medio al añadir para-dimetilaminobenzaldehído. Se utiliza un medio de cultivo rico en triptófano, como el agua de peptona, o, mejor aún, el agua de triptona, pero inmerso en una matriz semisólida como el Agar SIM (Indol, Movilidad y Sulfuro de Hidrógeno), que nos permitirá la lectura de éstas tres pruebas simultáneas. Se pueden utilizar dos reactivos:
1) Reactivo de Kovacs, y
2) Reactivo de Ehrlich.
En nuestra experiencia preferimos el primero, pero hay autores que aconsejan el segundo, especialmente para determinados anaerobios.
a) Reactivo de Kovacs:
- Alcohol amílico o isoamílico: 150 ml.
- Para-dimetilaminobenzaldehído: 10 g.
- Acido clorhídrico concentrado: 50 ml.
Disolver el aldehído en el alcohol y agregar lentamente el ácido con agitación constante. El reactivo es de color amarillo y se guarda protegido de la luz y a 4° C.
b) Reactivo de Ehrlich:
- Para-dimetilaminobenzaldehído: 2 g.
- Alcohol etílico de 95°: 190 ml.
- Ácido clorhídrico concentrado: 40 ml.
Se prepara y almacena de igual modo que el reactivo de Kovacs. Inocular una o dos colonias, con ansa de platino puntiforme, en el Agar SIM e incubar 24 – 48 horas a 37° C. Después de la incubación, añadir 5 gotas del Reactivo de Kovacs agitando suavemente. La aparición de un anillo de color rojo en la superficie del medio indica producción de indol. Si no se forma el anillo rojo, se considera la prueba negativa.
PRUEBA DE VOGES PROSKAUER Y ROJO DE METILO
Las Enterobacterias clínicamente importantes son anaerobias facultativas, y como tales, fermentan los hidratos de carbono. Se conocen dos sistemas de fermentación para las Enterobacterias:
Fermentación Acido Mixta: Producen Ácidos, CO2 y H2 , produciendo un gran descenso del pH.
Fermentación Butilenglicolica: Producen menor cantidad de ácidos y Butilenglicol (Acetilmetilcarbinol), el descenso de pH es mucho menos importante.Estas dos pruebas se suelen realizar al mismo tiempo y se se siembran simultáneamente en un mismo tubo con Caldo de Clark Lubs o Caldo Rojo de Metilo – Voges Proskauer (RMVP) que posteriormente se dividen en dos para realizar independientemente las pruebas. También se suelen considerar complementarias, así ambas pruebas no dan positivo a la vez.
VOGES PROSKAUER
Se basa en la capacidad que poseen determinados microorganismos de producir acetil – metil – carbinol a partir de la degradación de la glucosa mediante la fermentación Butilenglicolica. En presencia de oxígeno y de una solución de K(OH) al 40%, el acetil – metil – carbinol se convierte en diacetilo, el cual, en contacto con alfa – naftol produce color rojo. Se utiliza el Medio de Clark-Lubs o Caldo glucosa fosfato que es un medio comercializado como Caldo RMVP. Inocular con ansa de platino, 1 o 2 colonias en el caldo e incubar 24 – 48 horas a 37° C. Existen microorganismos que precisan de otra temperatura de incubación o de un tiempo más prolongado.
Después de la incubación añadir al caldo de cultivo 0,6 ml. de la solución de alfa – naftol, y a continuación 0,2 ml. de la solución de hidróxido potásico agitando unos instantes para favorecer un mayor contacto del líquido con el oxígeno del aire. La lectura se efectúa después de diez a quince minutos de añadir los reactivos, considerando como prueba positiva la aparición de una coloración roja.
ROJO DE METILO
Se funda en la capacidad que poseen algunos microorganismos de actuar sobre la glucosa, y a través del ácido pirúvico producir una fermentación ácido mixta, capaz de bajar el pH a una cifra igual o inferior a 4,4. Se utiliza el medio de Clark-Lubs descrito en la prueba de Voges-Proskauer, y como reactivo la Solución de rojo de metilo al 0,5 por 100 en alcohol de 60º. Inocular una colonia, con ansa de platino, en el caldo e incubar un mínimo de 48 horas a 37º C. Determinados microorganismos necesitan una incubación más prolongada. Después de la incubación, añadir cinco gotas del reactivo al caldo de cultivo. Se considera la prueba como positiva si aparece una coloración roja. Una coloración amarilla la califica como negativa, y una coloración anaranjada indica que la prueba es dudosa y que se deberá repetir.
PRUEBA DEL CITRATO
Determina la capacidad que poseen algunos microorganismos de utilizar como única fuente de carbono el citrato, produciendo alcalinidad. El medio utilizado es el agar citratado de Simmons. Se inocula en estría, en el pico de flauta, empezando desde el fondo hasta la parte más alta e incubar a 37° C durante veinticuatro a cuarenta y ocho horas. Son dos los aspectos que confirman la positividad de la prueba:
a) La observación de crecimiento sobre el pico de flauta.
b) La variación de coloración de verde a azul, debido a la alcalinización del medio, producida por la liberación de sodio del citrato utilizado, sodio, que con las moléculas de agua presentes formará Na(OH).
PRUEBA DE LA UREA
Determina la capacidad de un organismo para desdoblar la urea, en amoniaco y CO2, por acción de la enzima ureasa. La visualización del proceso se fundamenta en que la alcalinización producida en el medio de cultivo se detecta mediante un indicador de pH (rojo de fenol). Se utiliza una solución de urea al 20 por 100. Pesar 20 g. de urea deshidratada y disolverlos en 100 ml. de agua destilada. No debe calentarse la solución ya que la urea se desnaturaliza por el calor. Esterilizar por filtración, o utilizar erlenmeyer y agua destilada estériles. Como medio base se utiliza el Medio Urea de Christensen. Efectuar un inóculo denso en la zona del pico de flauta e incubar a 37° C durante veinticuatro a cuarenta y ocho horas. Se considera la prueba positiva si el medio adquiere una tonalidad rosada, y negativa si mantiene su coloración inicial.
PRUEBA DE LA DNasa
Se basa en la capacidad que poseen ciertas bacterias para hidrolizar enzimáticamente el ácido desoxirribonucleico, produciendo una mezcla de mono y polinucleótidos. Se utiliza el Agar DNA y como reactivo, el Ácido Clorhídrico 1 N. Sembrar una colonia del germen a investigar sobre una placa de Agar DNA, de forma que después de la incubación quede una estría superficial o un botón de crecimiento denso. Incubar 24 horas a 37° C. Cubrir las placas con HCl 1N. En caso de que el germen sea productor de DNasa, se observa una zona clara alrededor del crecimiento. En caso negativo, el medio permanece opaco.
PRUEBA DE LAS DESCARBOXILASAS
Algunas bacterias poseen unas enzimas descarboxilasas específicas que son capaces de atacar el grupo carboxilo de determinados aminoácidos, produciendo anhídrido carbónico y una amina, o diamina. Así la lisina decarboxilasa (LDC) produce, a partir de la L – lisina: cadaverina (una diamina) y CO2. La ornitina decarboxilasa (ODC) por acción sobre su L – aminoácido específico da putresceína (diamina) y CO2. El aminoácido L – arginina posee un sistema especial de transformación: primero por acción de una decarboxilasa se transforma en un producto intermedio, la agmatina, la cual, por una dihidrolasa pasa a putresceína y urea. Si el microorganismo es productor de ureasa transformará a su vez la urea en amoniaco y anhídrido carbónico. Se utiliza el universalmente conocido Medio de Möeller, que puede utilizarse como base para incluir cada uno de los aminoácidos. La inoculación se realiza con un inóculo liviano de veinticuatro horas de crecimiento, se cubren los tubos con 2 ó 3 mI. de parafina estéril para evitar que el pH varíe (incluso en el patrón) y se incuban a 37° C por hasta cuatro días. Se considera el resultado positivo cuando se observa una coloración púrpura turbia. Una coloración amarilla (debida a la actuación de la bacteria sobre la glucosa dando ácido) indicará que la prueba es negativa.
PRUEBA DE LA LISINA – HIERRO
En el medio de cultivo (Agar Lisina Hierro), la peptona y el extracto de levadura aportan los nutrientes para el desarrollo bacteriano. La glucosa es el hidrato de carbono fermentable, y la lisina es el sustrato utilizado para detectar la presencia de las enzimas decarboxilasa y deaminasa. El citrato de hierro y amonio, y el tiosulfato de sodio, son los indicadores de la producción de ácido sulfhídrico. El púrpura de bromocresol, es el indicador de pH, el cual es de color amarillo a pH igual o menor a 5.2, y de color violeta a pH igual o mayor a 6.8. Por decarboxilación de la lisina, se produce la amina cadaverina, que alcaliniza el medio y esto produce el viraje del indicador al color violeta. La decarboxilación de la lisina, tiene lugar en medio ácido, por lo que es necesario que la glucosa sea previamente fermentada. Los microorganismos que no producen lisina decarboxilasa, pero que son fermentadores de la glucosa, producen un viraje de la totalidad del medio de cultivo al amarillo, pero a las 24 hs de incubación se observa el pico de color violeta debido al consumo de las peptonas, y el fondo amarillo.
La producción de sulfuro de hidrógeno, se visualiza por el ennegrecimiento del medio debido a la formación de sulfuro de hierro. Las cepas de los géneros Proteus, Providencia y algunas cepas de Morganella, desaminan la lisina, esto produce un ácido alfa-ceto-carbónico, el cual, con la sal de hierro y bajo la influencia del oxígeno forma un color rojizo en la superficie del medio. Se siembra por punción profunda con aguja de inoculación, incubándose en aerobiosis, durante 24 horas a 37 °C.
- Prueba Positiva: Pico violeta/fondo violeta.
- Prueba Negativa: Pico violeta/fondo amarillo.
- Pico rojizo / fondo amarillo. Esto sucede con cepas del género Proteus, Providencia y alguna cepas de Morganella spp.
- Prueba positiva de producción de ácido sulfhídrico: Ennegrecimiento del medio (especialmente en el límite del pico y fondo)
Microorganismos
Color en el pico de flauta
Color en la base del tubo
Ennegrecimiento del medio
Proteus mirabilis ATCC 43071
Rojo
Amarillo
Negativo
Salmonella typhimurium ATCC 14028
Púrpura
Púrpura
Positivo
Salmonella enteritidis ATCC 13076
Púrpura
Púrpura
Positivo
Providencia spp.
Rojo
Amarillo
Negativo
Citrobacter freundii
Púrpura
Amarillo
Positivo
Morganella spp.*
Rojo
Amarillo
Negativo
Edwarsiella spp.
Púrpura
Púrpura
Positivo
Klebsiella pneumoniae ATCC 700603
Púrpura
Púrpura
Negativo
Escherichia coli ATCC 25922
Púrpura
Púrpura
Negativo
*Algunas especies de Morganella spp., pueden desaminar la lisina.
PRUEBA DE MANITOL y MOVILIDAD
Se utiliza un medio semisólido el Agar SIM para detectar la movilidad, la producción de ácido sulfhídrico o sulfuro de hidrógeno y el indol de las bacterias. Este medio puede contener manitol como fuente de carbono. Si el microorganismo es capaz de usar el manitol se produce una acidificación del medio, lo que da lugar a un viraje del indicador de pH de rojo a amarillo. Inocular por picadura un tubo de medio semisólido con cada uno de los distintos microorganismos aislados. Incubar 24 horas a 37°C y observar la zona de crecimiento del microorganismo y si ha habido cambio en la coloración del medio. El test de la movilidad se hace mirando el desplazamiento del microorganismo. Si el crecimiento se limita a la zona de la picadura, el microorganismo no es móvil. Si el crecimiento se produce por todo el medio, el microorganismo es móvil.
PRUEBA DE REDUCCIÓN DEL NITRATO
Algunos microorganismos utilizan el nitrato en una vía alternativa como fuente de energía, reduciéndolo a nitrito o a nitrógeno libre. Esta propiedad es una característica importante en la diferenciación de muchos grupos bacterianos. La presencia de nitrito en el medio se demuestra añadiendo alfa – naftilamina y ácido sulfanílico, con la formación de un compuesto rojo: el parasulfobencenoazo – alfa – naftilamina. Utilizaremos el medio Manitol Movilidad, con los siguientes reactivos:
Reactivo A:
Alfa-naftilamina: 5 g.
Acido acético 5N al 30 por 100: csp 1.000 mlReactivo B:
Acido sulfanílico: 8 g.
Acido acético 5N al 30 por 100: csp 1.000 mlMantener los reactivos A y B en frasco oscuro y en la heladera sin congelar. Sembrar por picadura e incubar a 37° C durante 24 – 48 horas. Añadir 0,5 ml. de reactivo A y a continuación 0,5 ml. del reactivo B. La aparición de un color rojo después de treinta segundos indica la presencia de nitritos en el medio. La reducción de los nitratos puede dar otros productos más reducidos como amoniaco, nitrógeno molecular, óxido nítrico, óxido nitroso o hidroxilamina, dependiendo de la especie bacteriana, en tal caso, después de la adición del reactivo, no se aprecia cambio de color en el medio. Para confirmar que el proceso es negativo es necesario añadir una pequeña cantidad de polvo de zinc, el cual, en caso de que existan nitratos, los reducirá a nitritos, volviendo el medio de color rojo, e indicando consecuentemente que antes no se había producido la reacción. Si después de la adición del polvo de zinc el color no vira a rojo, indica que ha habido reducción y que el producto obtenido no ha sido el nitrito.
PRUEBAS CON AGAR TRIPLE AZÚCAR – HIERRO (Agar TSI)
Son medios utilizados preferentemente para la diferenciación de la familia Enterobacteriaceae. En ellos se puede determinar las fermentaciones de los hidratos de carbono, la producción de gas y de ácido sulfhídrico. El Agar TSI contiene tres azúcares: glucosa y sacarosa (10 por 100) y lactosa (1 por 100). Con una aguja de inoculación se toma una colonia aislada y se siembra por picadura hasta unos 0,6 cm. del fondo. Se retira la aguja siguiendo el mismo camino de entrada y, sin volver a cargar el asa, se siembra en estría la superficie del pico de flauta. Incubar a 37° C durante veinticuatro horas. Es importante respetar estos tiempos de incubación, ya que lecturas de menor o mayor incubación pueden dar resultados falsamente positivos o negativos. Se tendrán en cuenta los siguientes aspectos:
a) Producción de ácido a partir de la glucosa: Se pone de manifiesto en la parte inferior del medio al producirse un cambio de color debido al viraje del indicador de pH que pasa de rojo-naranja a amarillo (ácido).
b) Producción de gas a partir de la glucosa: Los gases producidos son el CO2 y el H2, productos terminales del metabolismo de la glucosa, que se aprecia por la aparición de burbujas en la parte inferior del medio, por una producción de grietas en su interior o incluso por una elevación del medio que se separa del fondo.
c) Producción de ácido a partir de la lactosa: Se aprecia por un cambio de color de rojo a amarillo en la parte del pico de flauta del medio.
d) Producción de sulfhídrico: Se manifiesta por un ennegrecimiento del medio en la línea de inoculación o sobre la capa superficial.
En cultivos de bacterias muy productoras de SH2 a veces llega a ennegrecer todo el medio, ocultando la reacción ácida de la parte inferior del medio (tubo), pero si se ha formado SH2 es que existe una condición ácida en esa zona por lo que se considerará el resultado, de la producción de ácido a partir de la glucosa, como positivo.
PRUEBA DE LA FENILALANINA
Esta prueba determina la capacidad de un organismo para desaminar el aminoácido fenilalanina en ácido fenilpirúvico por su actividad enzimática de fenilalanina desaminasa, con la consiguiente acidez resultante. Esta actividad enzimática es característica de todas las especies del género Proteus y del grupo Providencia por lo que se usa para separar ambos géneros de otras Enterobacterias. Se cultiva el microorganismo en Agar fenilalanina sembrando la superficie del pico de flauta con abundante inóculo e incubando durante 16 horas. Seguidamente se añade 0,2 ml de una solución de cloruro férrico al 10% de manera que inunde todo el crecimiento. La presencia de ácido fenilpirúvico (prueba positiva) se manifiesta por la aparición de un color característico verde oscuro o verde-azulado. La fenilalanina es un aminoácido que por desaminación oxidativa forma un cetoácido, el ácido fenilpirúvico. Sólo los géneros Proteus y Providencia poseen la fenilalanina desaminasa, lo que permite diferenciarlas del resto de las Enterobacterias. La prueba de la fenilalanina se basa en la detección del ácido fenilpirúvico luego del desarrollo del germen en un medio que contiene fenilalanina. Para eso se agrega cloruro férrico que forma un complejo de color verde con el ácido fenilpirúvico. El medio de cultivo no puede contener extractos de carne o peptonas por su contenido variable en fenilalanina.
API 20E y SIMILARES
La batería de pruebas API20E es un sistema de identificación rápida para bacterias de la familia Enterobacteriaceae y otras bacterias Gram(-). Básicamente consta de 23 tests bioquímicos estandarizados y miniaturizados y una base de datos. Este sistema presenta las ventajas de ser rápido, eficaz y de permitir realizar numerosas pruebas a la vez. Cada tira de API 20E contiene 20 microtubos o pocillos con distintos sustratos deshidratados. Cada tubo es una prueba bioquímica. Los microtubos se inoculan con una suspensión de microorganismos, en agua o solución salina, que rehidrata los medios. Las tiras se incuban a 37°C y por efecto del metabolismo bacteriano se van a producir cambios de color espontáneos o bien al añadir reactivos. La lectura de las reacciones se hace mediante comparación con una tabla de lectura donde se indica si los microorganismos deben considerarse positivos o negativos para cada reacción según el color aparecido. Tomar una colonia bien aislada de cada microorganismo y suspenderla homogéneamente en 5 ml de solución salina (1% de ClNa) o 5 ml de agua estéril. Poner la tira en la cámara de incubación. Previamente poner agua en los alvéolos de la cámara para proporcionar una atmósfera húmeda durante la incubación. Cada pocillo tiene un tubo y una cúpula. Llenar el tubo y la cúpula de los pocillos | CIT | , | VP |, | GEL | con la suspensión de bacterias. Llenar los tubos, no la cúpula, de los demás pocillos. Llenar con parafina las cúpulas de los pocillos ADH, LDC, ODC, URE, H2S para obtener anaerobiosis. Incubar a 37 °C durante 18 – 24 h. La lectura de los resultados se lleva a cabo por comparación de los colores de cada pocillo con los de la tabla de lectura. Del conjunto de reacciones y resultados se obtiene un perfil numérico. Los pocillos están separados en grupos de tres: en total tenemos 7 tripletes (el test número 21 corresponde al test de la oxidasa). A cada pocillo se le da el valor 0, 1, 2 o 4. Si la reacción es negativa se pone 0. Si la reacción es positiva se pone: 1 si es el primer pocillo de un triplete, 2 si es el segundo, 4 si es el tercero. Se suman los valores de cada triplete y se obtiene un código de 7 cifras. Con este código se busca en la tabla de identificación la especie de que se trata.
"SOMOS LO QUE HACEMOS REPETIDAMENTE. EXCELENCIA, POR LO TANTO, NO ES UN ACTO SINO UN HÁBITO"
ARISTOTELES
LEGALES: El autor no asume responsabilidad alguna por la descarga, copia, distribución, modificación o alteración de los contenidos publicados, sean propios del mismo o de terceros, los cuales pudieren estar protegidos por Copyright, Derechos de Propiedad Intelectual, Derechos de Autor, o relacionados. La Bibliografía del tema expuesto y el crédito fotográfico está en poder del Autor y no se publica dada su extensión, pero se enviará por mail al interesado que la solicitare debidamente fundamentada.